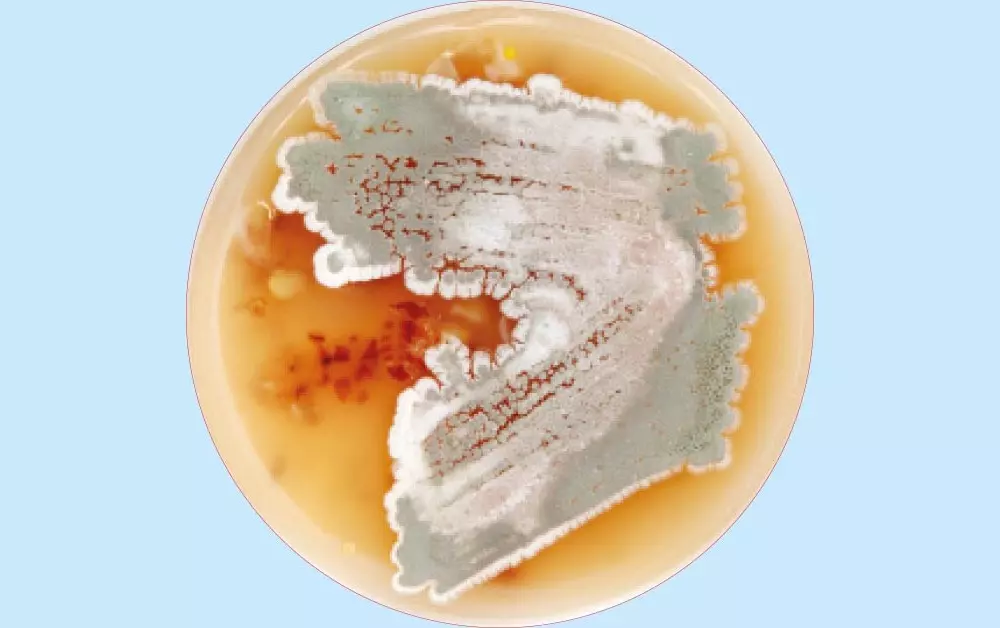

Menu

Nr 19
Styczeń 2017
Styczeń 2017
Zawartość dostępna online
AKADEMIA ROZWOJU
- Małgorzata Łuba
- 31 lipca 2018
- Małgorzata Łuba
- 31 lipca 2018
- Małgorzata Łuba
- 31 lipca 2018
CO NOWEGO W BIOLOGII?
- Krzysztof Dudek , Prof. dr hab. Piotr Tryjanowski
- 31 lipca 2018
EKOLOGIA
LABORATORIUM
- Marek Ples
- 6 sierpnia 2018
MIKROBIOLOGIA
NEUROBIOLOGIA
POMYSŁ NA LEKCJĘ
- Alina Jakubowska
- 31 lipca 2018
TEMAT NUMERU
Z KSIĘGARSKICH PÓŁEK
ZE ŚWIATA ZOOLOGII
- Marek Stajszczyk
- 30 lipca 2018